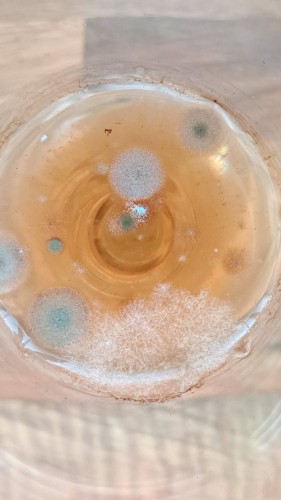
Na 1 week

Na 1 week
Onvoorstelbaar hoe snel schimmels zich kunnen ontwikkelen
Sharing = earning
1,000,000 views = € 1,000
100,000 views = € 100
10,000 views = € 10
1,000 views = € 1
500 views = € 0.50
250 views = € 0.25
100 views = € 0.10
50 views = € 0.05
25 views = € 0.025
10 views = € 0.01
And much more
- Comments (1)
- Recommended
- Milestones

Frutselen in de Marge
1 year ago
ik verwacht over 3 weken een groene drip
Here are your recommended items...
Here are your milestones...